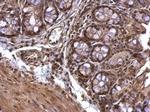
Acetylcholinesterase Antibody in Immunohistochemistry (Paraffin) (IHC (P))
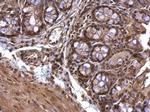
Acetylcholinesterase Antibody in Immunohistochemistry (Paraffin) (IHC (P))

Search
Invitrogen
Acetylcholinesterase Polyclonal Antibody
{{$productOrderCtrl.translations['antibody.pdp.commerceCard.promotion.promotions']}}
{{$productOrderCtrl.translations['antibody.pdp.commerceCard.promotion.viewpromo']}}
{{$productOrderCtrl.translations['antibody.pdp.commerceCard.promotion.promocode']}}: {{promo.promoCode}} {{promo.promoTitle}} {{promo.promoDescription}}. {{$productOrderCtrl.translations['antibody.pdp.commerceCard.promotion.learnmore']}}
图: 1 / 17
Acetylcholinesterase Antibody (PA5-21371) in ICC/IF

产品信息
PA5-21371
宿主/亚型
分类
类型
抗原
偶联物
形式
浓度
保存条件
运输条件
RRID
产品详细信息
Recommended positive controls: Raji, mouse brain, rat brain.
Predicted reactivity: Mouse (89%), Rat (88%), Cat (95%), Rhesus Monkey (98%), Bovine (94%), Guinea pig (92%).
Store product as a concentrated solution. Centrifuge briefly prior to opening the vial.
靶标信息
Acetylcholinesterase hydrolyzes the neurotransmitter, acetylcholine at neuromuscular junctions and brain cholinergic synapses, and thus terminates signal transmission. The Protein is also found on the red blood cell membranes, where it constitutes the Yt blood group antigen. Acetylcholinesterase exists in multiple molecular forms which possess similar catalytic properties, but differ in their oligomeric assembly and mode of cell attachment to the cell surface. The major form of acetylcholinesterase found in brain, muscle and other tissues is the hydrophilic species, which forms disulfide-linked oligomers with collagenous, or lipid-containing structural subunits.
仅用于科研。不用于诊断过程。未经明确授权不得转售。



